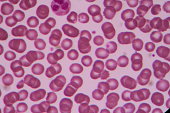

A small research examined the effects of B. coagulans on a bunch of 45 rheumatoid arthritis patients. It’s been studied sporadically in a number of areas, comparable to rheumatoid arthritis and IBS, however extra analysis is required in all areas. Probiotics support all elements of canine health and are usually given as a supplement with food to regulate gastrointestinal functioning by guaranteeing more “good” micro organism than “bad” micro organism in the intestines. Purpose: Bacillus coagulans-primarily based probiotics restore intestine microbiota and alleviate signs of gastrointestinal (GI) discomfort. Zhang, Y.; Li, M.; Nie, T.; Ni, Z. A Process Study of Lactic Acid Production from Phragmites australis Straw by a Thermophilic Bacillus coagulans Strain under Non-Sterilized Conditions. It has additionally been noted that in situations like eczema and certain meals allergies, there’s an hostile steadiness of intestinal bacteria with marked discount in lactic acid micro organism and a rise in putrefactive pathogens within the faecal flora. The UHC predicted for matric suctions of 500 and 1,500 kPa initially decreased for B. coagulans suspension density up to 1.2×109 cells/ml for BC and FX fashions, with the exception of some instances, but thereafter increased with increase in microbial density.
Co-administration of B. coagulans GBI-30, 6086 with protein has been proven to increase protein absorption and to maximise the well being advantages related to protein supplementation. There is only somewhat research to help the well being advantages of Bacillus coagulans. Bacillus coagulans is widely used in the cosmetics and personal care industry due to its monumental advantages for treating pores and skin situations reminiscent of acne and anti-aging disorders. Another theory proposed by Allan L. Lorincz steered that oxidative breakdown of lipids and squalene was a cause of acne fairly than a consequence. If you adored this article so you would like to collect more info relating to high-quality bacillus coagulans kindly visit our own internet site. 42) Finally, whereas analysis isn’t but conclusive, it has been urged that an overgrowth of histamine-producing micro organism in the gut may contribute to histamine intolerance. LactoSpore® is Biomed’s bacteria of alternative, and we would like you to know exactly why we choose to use this explicit strain in our Daily Digestive Support Supplement. 30 in each arm) with out a selected pathology have been randomized to obtain B. coagulans-SNZ 1969, TriBac, or placebo, as soon as daily after a significant meal, for 30 days. Adults & Children Ages 12 & Over Take One Capsule Daily With Water. Safety and tolerability of B. coagulans MTCC 5856 was assessed over 30 days by security laboratory parameters (blood hematology and clinical chemistry parameters), anthropometric measures (weight, BMI, blood pressure and heart price), antagonistic events, Bristol stool rating, tolerability questionnaire and bowel behavior diary.
Objective: LactoSpore® containing probiotic pressure Bacillus coagulans MTCC 5856 has been marketed as a dietary ingredient for almost two decades. Lactic acid bacteria are thus extra appropriate to be used in a wide range of processed foods and dietary supplements. Spore forming lactic acid bacteria can generate spores and are rather more stable, and in addition extra efficient at producing lactic acid. If you wish to grab some fundamental information about this supplement, you may see it right here because the beneath factors will help you study it nicely with correct understanding. Moreover, we goal at establishing a consolidated bioprocess (CBP), through which this pressure can be tested for the simultaneous manufacturing of depolymerizing enzymes and the fermentation of sugars to L-lactic acid, thus enormously lowering the costs of your complete production course of. That is each important and relevant in the setting of acne as squalene, a key element in the formation of the comedone, is delicate to oxidative stress. Faulty antioxidant response seen in acne patients gives yet one more function for probiotics within the remedy of acne.
The approval of TechnoSpore® within the European Union provides animal nutritionists and farmers with a new effective probiotic to support health and efficiency in monogastric animals. 60-Day Money-Back Guarantee: Neotonics provides a security internet with a 60-day cash-back guarantee. This examine evaluated the efficacy and security of SNZ 1969 in people with GI discomfort. Clinical knowledge on the security and tolerance has not been evaluated at a dose of 2×109 cfu (spores)/day in healthy people. In this study, Bacillus coagulans MTCC 5856 spores have been characterised for potential probiotic attributes of survival during digestion, adhesion to gastro intestinal lining cells and immunostimulation. Participants additionally reported that B. coagulans MTCC 5856 tablets were tolerable and straightforward to swallow. Although able to infect larvae under certain conditions, B coagulans is probably not the reason for HMD. It’s no surprise why bacillus coagulans (in any other case often called B. coagulans) has captured the scientific consideration of analysis groups and meals manufacturers alike. A comparative examine of soil-water characteristic curves (SWCCs) for compacted lateritic soil ̶ Bacillus coagulans (B. Study design: A complete of 40 individuals had been randomized into one among two groups in a double-blind, randomized, placebo-managed parallel study. Treatment with SNZ 1969 significantly improved the total SODA rating (18.34 ± 5.35 vs.